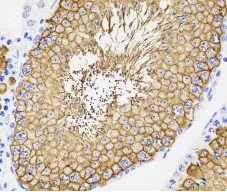
Animal Testicular Tissue Fixative Solution1 Animal Testicular Tissue Fixative Solution1

পণ্য তথ্য
|
পণ্যের নাম |
বিড়াল না. |
স্পেক |
| পশু টেস্টিকুলার টিস্যু ফিক্সেটিভ সলিউশন |
G1121-15ML |
15 মিলি |
|
G1121-500ML |
500 মি.লি |
পণ্য বিবরণ
হিস্টোপ্যাথোলজিতে, পরবর্তী এমবেডিং এবং বিভাগগুলি সম্পূর্ণ করার আগে টিস্যুকে অবিলম্বে এবং কার্যকরভাবে স্থির করতে হবে। সংস্থার স্থির ভূমিকা হল সংগঠন, কোষের অন্তর্নিহিত অঙ্গসংস্থানবিদ্যা এবং কাঠামো বজায় রাখা, ব্যাকটেরিয়া ক্ষয় এবং টিস্যু অটোলাইসিস প্রতিরোধ করা, কোষের ভিতরে অন্তর্নিহিত উপাদান সংরক্ষণ করা, কোষের প্রোটিন জমাট বাঁধা, যতদূর সম্ভব অন্তঃসত্ত্বা এবং বহিরাগত এনজাইম বিক্রিয়া কমানো বা শেষ করা। , কোষ বা টিস্যু মূলত জীবন্ত উপাদান মত রাখা, এছাড়াও সংগঠন কঠিনীভূত করতে পারেন, সংগঠনের কাটা মেরামত করা সহজ. নির্দিষ্ট সংক্রামক নমুনার জন্য, রোগের বিস্তার রোধ করতে পারে; স্থূল নমুনা সংরক্ষণ করুন. অবশেষে, ফিক্সেশন স্টেনিংয়ের প্রভাবকে বাড়িয়ে তুলতে পারে। শক্তিশালী অনুপ্রবেশ, অভিন্ন স্থিরকরণ, টিস্যু সংকোচন এবং উপযুক্ত কঠোরতা সহ ফর্মালডিহাইড হল সবচেয়ে বেশি ব্যবহৃত ফিক্সেটিভ, যা বেশিরভাগ টিস্যুর নমুনার স্থিরকরণের জন্য উপযুক্ত।
টেস্টিকুলার টিস্যুর প্রথাগত ফিক্সেশন পদ্ধতি হল বাউইনের ফিক্সেশন দ্রবণ, কিন্তু এই ফিক্সেশন দ্রবণটি অম্লীয় এবং অ্যান্টিজেন এবং নিউক্লিয়ার স্টেনিং-এর উপর দারুণ প্রভাব ফেলে, যা উল্লেখযোগ্যভাবে প্রভাবিত হয়। প্যারাফর্মালডিহাইড দ্রবণ দিয়ে স্থির টেস্টিকুলার টিস্যু আন্তঃস্থায়ী ক্ষতির প্রবণ ছিল। এই ফিক্সেটিভটি বিশেষভাবে দ্রুত অনুপ্রবেশের সাথে প্রাণীর টেস্টিস টিস্যুর ফিক্সেশনের জন্য ব্যবহৃত হয়, যা টিস্যুর গঠনকে অক্ষত রাখতে পারে, বেশিরভাগ অ্যান্টিজেন ধরে রাখতে পারে এবং নিউক্লিয়াসের দাগকে প্রভাবিত করে না এবং আইএইচসি সনাক্তকরণকে প্রভাবিত করে না। অথবা IF এই পণ্যের প্রধান উপাদানগুলি হল ফর্মালডিহাইড দ্রবণ, ইথানল এবং গ্লাসিয়াল অ্যাসিটিক অ্যাসিড।
স্টোরেজ এবং হ্যান্ডলিং শর্তাবলী
কক্ষ তাপমাত্রায় পরিবহন; একটি শীতল এবং শুষ্ক জায়গায় সংরক্ষণ করুন, সরাসরি সূর্যালোক থেকে দূরে, 24 মাসের জন্য বৈধ।
অ্যাস প্রোটোকল
ইঁদুরের টেস্টিকুলার টিস্যু অবিলম্বে পর্যাপ্ত পরিমাণে ফিক্সেটিভ দ্রবণে রাখা হয়েছিল, ঘরের তাপমাত্রায় 20-24 ঘন্টার জন্য স্থির করা হয়েছিল, এবং তারপর সংরক্ষণের জন্য 70% ইথানলে স্থানান্তরিত হয়েছিল।
ইঁদুর এবং অন্যান্য প্রাণীদের টেস্টিকুলার টিস্যু তুলনামূলকভাবে বড়। পুঙ্খানুপুঙ্খভাবে অনুপ্রবেশ নিশ্চিত করার জন্য, একটি ধারালো ব্লেড দিয়ে টিস্যুটিকে যথাযথ আকারে কাটা যেতে পারে, বা বাইরের ঝিল্লিটিকে একটি সুই দিয়ে আলতো করে খোঁচানো যেতে পারে এবং তারপরে পর্যাপ্ত পরিমাণে ফিক্সিং দ্রবণে রাখা যেতে পারে, যা 20-24 ঘন্টার জন্য স্থির করা হয়। , যতদূর সম্ভব 48 ঘন্টার বেশি নয়, এবং তারপর সংরক্ষণের জন্য 70% ইথানলে স্থানান্তরিত করা হয়।
দ্রষ্টব্য
1. ইনহেলেশন এড়াতে যথাযথ সুরক্ষা সহ একটি ভাল বায়ুচলাচল পরিবেশে পণ্যটি ব্যবহার করুন।
2. টিস্যু ফিক্সেশনের সময় 48 ঘন্টার মধ্যে নিয়ন্ত্রণ করা উচিত, এবং তারপরে স্টোরেজ বা পরিবহনের জন্য 70% অ্যালকোহলে স্থানান্তরিত করা উচিত, অন্যথায় টিস্যু গঠন বা প্রোটিন ইমিউনোডেটেকশন ফলাফল প্রভাবিত হতে পারে।
3. উদ্বায়ী সক্রিয় উপাদান প্রতিরোধ করার জন্য ব্যবহারের পরে সময়মতো ক্যাপ শক্ত করুন।
4. আপনার নিরাপত্তা এবং স্বাস্থ্যের জন্য, কাজ করার সময় দয়া করে একটি ল্যাব কোট এবং ডিসপোজেবল গ্লাভস পরিধান করুন।
ছবি

উত্তর: মাউস টেস্টিস, 20 ঘন্টার জন্য স্থির, প্যারাফিন বিভাগগুলি HE,40X দিয়ে দাগযুক্ত ছিল।
বি:মাউস টেস্টিস, 20 ঘন্টার জন্য স্থির, প্যারাফিন বিভাগগুলি HE,400X দিয়ে দাগযুক্ত ছিল।

C: মাউস টেস্টিস, 20 ঘন্টার জন্য স্থির, প্যারাফিন বিভাগটি IHC (GB11294), 400X দ্বারা GluT3 সনাক্ত করতে ব্যবহৃত হয়েছিল।
গরম ট্যাগ: পশু টেস্টিকুলার টিস্যু ফিক্সেটিভ দ্রবণ, চীন পশু টেস্টিকুলার টিস্যু ফিক্সেটিভ সমাধান প্রস্তুতকারক, সরবরাহকারী, কারখানা






